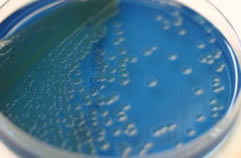
培地上に形成されたコロニー

中央検査部
生化学検査室
検査内容
- 生化学部門
- 肝機能や腎機能などを検査
- 免疫血清部門
- 腫瘍マーカーや肝炎ウイルスなどを検査
どうして血液検査前に食べたり飲んだりしてはいけないのでしょう?
皆さん、『採血をする時は出来るだけ飲食は控えて下さい』と医師や看護師に言われたことがあると思います。一体どうしてでしょうか?実は飲食により検査値が変わってしまう項目があります。
検査値が増加する項目 ・・・・ 中性脂肪、血糖など
検査値が減少する項目 ・・・・ 遊離脂肪酸、無機リンなど
例えば、採血の当日や前日の夜遅くに飲食をすると、中性脂肪が血中に多く取り込まれるため、翌日の採血では血清(血液の液体成分)が真っ白になってしまい、検査結果に影響を及ぼすことがあります。
生化学検査室で活躍中の機器をお見せします。
これらの機器で、肝機能や腎機能などの生化学検査、腫瘍マーカーなどの免疫血清検査を行っています。多項目同時測定が可能で、緊急検査にも対応しています。


輸血検査室
検査内容
- 血液型検査
- 交差適合試験
- クームス試験
- 不規則抗体検査
輸血検査室の仕事
血液型といえばABO式血液型が有名ですが、その他にもいろいろな血液型があり、検査をしています。また、輸血を行う前に輸血する血液と患者さんの血液がきちんと合っているかどうかを調べ、適切な血液を輸血できるようにしています。
自分の血液型を知っていますか?
あなたは、自分の血液型が何型か知っていますか?血液型は人種や地域によって差があるといわれています。日本人は、A型:O型:B型:AB型=4:3:2:1となっています。ABO式血液型以外に重要といわれているのが、Rh式血液型(特にD抗原)です。日本人は99.5%の人がRhD陽性ですが、0.5%の人はRhD陰性です。輸血の際には、原則としてABO型とRhD型を合わせた血液を輸血します。

このようにABO式の血液型は、それぞれ違う反応を示します。
血液検査室
あなたは「血液検査」と聞いて何を思い浮かべますか?
血液型?血糖値?それともコレステロール?それらを調べるのも臨床検査技師の仕事ですが、私たち血液検査室では主に、血液中の細胞数や、貧血の有無を調べたり、血液の固まりやすさを調べたりしています。
CBC(全血球計算)
多項目自動血球分析装置を使用して血液中の赤血球や白血球などの数を測定します。 貧血の有無もここで迅速に検査することができます。
主な検査項目

形態検査(末梢血・骨髄)
顕微鏡を使用して、血液中の細胞数を目視でカウントします。
より血液の疾患について詳しく検査する場合には骨髄(血液を作っている工場)の細胞も目視でカウントします。

凝固検査
血液には固まるという性質がありますが、これに関わる様々な物質・因子の検査を行なっています。
血液が固まって血栓ができやすくなっている状態や、お薬で血液をサラサラにされている場合などに凝固検査をすることで、血液の固まりやすさの状態を調べることができます。
検査項目
血小板凝集能
ケガをしたときなどに血を止めるために必要な血小板自体の働く力の強さを調べます。
血栓ができないように血小板の力を弱くするお薬を飲まれている場合には、検査をすることでお薬の量が適切かどうかを判断する元となります。
これらのことについて検査するのが私たち血液検査室の仕事です。このように、皆さんが痛い思いをして採血されたその血液からは、様々なことが分かるのですよ。
細菌検査室
検査内容
細菌検査は感染症の診断・治療に欠かせない大切な検査です。
感染症の原因となる病原菌を体の中から見つけ出し、その病原菌にどんな薬剤(抗生剤)が効くのか調べる仕事を行っています。検査に用いられる材料は尿・痰・便・血液・膿など体中のあらゆるものが対象となります。
塗抹・染色検査
菌を染めて「見る」

検体をスライドグラスに塗り、グラム染色を行うと菌が特定の色に染まって観察されます。肉眼では見えないので顕微鏡を使って観察します。この時点で感染症の起炎菌を推定します。
また、グラム染色の他に、結核菌を染めるチール・ネルゼン染色も行っています。
培養検査
菌を増やす!
 培地と呼ばれる寒天に菌を発育させ、肉眼で観察できる菌のかたまり(コロニー)を形成させます。通常、24~72時間ほど要します。
培地と呼ばれる寒天に菌を発育させ、肉眼で観察できる菌のかたまり(コロニー)を形成させます。通常、24~72時間ほど要します。
同定検査
菌の名前を突き止める!
培地上に形成されたコロニーをよく観察し病原菌と推定されるものは、その菌の生化学的な反応(糖の分解や、酵素の産生など)を調べ、正確な菌の名前を決めます。
近年、質量分析装置(MALDI-TOF MS)による迅速同定が可能となり、当院でも 2017 年 4 月から稼働しています。この装置を導入したことによって原因となる菌の名前が短時間でわかり、より早く適切な治療を行うことが可能です。

薬剤感受性検査
どんな薬が効くか!

菌に効く薬剤を調べます。菌の種類によって有効な薬剤が異なります。いろいろな種類の薬剤があるため、一度に何種類か組み合わせて調べます。結果が出るまで24~48時間かかります。
迅速検査
スピーディーに結果を報告!

近年では、菌を培養せず、検体から直接病原体(抗原)を検出する方法がたくさん開発されています。 代表的なものは、インフルエンザウイルスや、RSウイルス、 ヒトメタニューモウイルスなどに用いる検査キットです。 手技が簡単なうえ、検査時間も数分から 15 分程度です。
院内感染対策
院内感染の監視!
細菌検査室では、感染制御支援システムを導入し、患者さんから検出された菌の情報を一元管理しています。「いつ、どこで、誰から、どのような菌が検出されたか」をリアルタイムに把握し、病院全体の感染対策に貢献しています。
また、感染対策チーム(ICT)の一員として、サーベイランス、院内ラウンドなど感染制御のために日々活動しています。
生理機能検査室
主な検査内容
- 心電図検査
- 肺機能検査
- 超音波検査
- 脳波検査
- 筋電図検査
- 睡眠時無呼吸検査
- ABI・PWV検査
生理検査機能ってなあに?
…… そんなあなたの質問にお答えします
Q:心電図検査ってビリビリ電気が流れるんですか?
A:流れませんのでリラックスしてくださいね。
Q:肺機能検査って苦しいんですか?
A:苦しいですができる限りがんばってみましょう。
Q:超音波検査って体に害はないですか?
A:体に害は無いのでくり返し検査できます。
Q:脳波検査では頭の良し悪しがわかるんですか?
A:残念ながら(?)わかりません。

各検査についてカンタンに説明しましょう。
心電図検査
両手両足のほか胸の6ヵ所に電極をつけて心臓から生じる電気信号をとらえています。
肺機能検査
肺に入る量や吐き出すことのできる息の量や速さ等を測定します。
脳波検査
頭に電極をはりつけて、脳の神経細胞から流れる微弱な電気をキャッチして波形にしています。その神経細胞が正常に機能しているかどうかを調べています。
超音波検査
超音波を発する探触子(プローブ)を体に当てて超音波を発信し、臓器の状態によって変化した反射波を画像化して診断します。
筋電図検査
活動電位を記録して、疾患の原因が筋肉か神経かを調べます。
睡眠時無呼吸検査
装置をつけて一晩過ごし、呼吸の状態と睡眠の状態を同時に調べます。
ABI・PWV検査
両手・両足首の血圧を同時に測定し、動脈がつまってないか、血管壁が硬くなってないかを調べます。
病理検査室
病理組織検査
手術や内視鏡などで取り出された病変部を薄くスライスし、着色して、病理医が顕微鏡で見て診断を行います。病気の良悪性の判断、がんの進行度、今後の手術や治療などを左右する重要な検査です。

薄切風景

胃がんの組織
一般検査室
尿検査
尿検査は、尿を採取するだけで調べられるので、受診者の体に負担がかからず、たいへん簡便な検査です。しかも、全身のさまざまな病気の発見に役立ちます。
尿定性検査

尿検査試験紙での反応
尿中に出ているタンパク、糖、赤血球、白血球、ケトン体、ウロビリノーゲンなどを調べることにより、体の代謝異常や腎臓・肝臓の機能、膀胱や尿道の炎症などを検査します。
顕微鏡による検査(沈渣)

尿を遠心してできた沈殿物を、顕微鏡で観察する検査です。赤血球や白血球がどれくらいあるのか数を数えたり、形状を観察したり、結晶や異常な細胞が出ていないかを確認します。
便潜血反応
便中に血液が含まれているかどうかを調べる検査です。陽性の場合は消化管の出血が考えられ、がん・ポリープ・潰瘍などの病変の可能性があります。
寄生虫卵検査
生肉・生魚を食べたり、海外に旅行に行ったりすることで寄生虫に感染することがあります。便に寄生虫の卵があるか顕微鏡で観察し、感染の有無を調べます。
生殖医療室



生殖医療室では体外受精などの不妊治療を行っています。卵子や精子を体外に取り出して受精・培養をし、育った受精卵を子宮内に戻しています。不妊に悩む患者さんが妊娠できるようお手伝いをしています。
